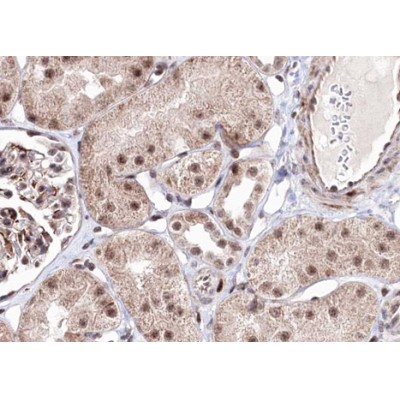
Валидация Affinity AF3494 - 2027

| Каталожный номер |
AF3494 |
| Название антигена |
Protein Kinase, AMP Activated Beta 1 (PRKAb1) |
| UNIPROT |
Q9Y478 |
| Иммуноген |
Синтетический пептид, соответствующий human AMPK ЙЗ1 в районе сайта фосфорилирования Ser181 |
| Английские синонимы |
AMPK, HAMPKb, 5"""-AMP-Activated Protein Kinase Subunit Beta-1 Non-Catalytic Subunit, Adenosine Monophosphate Activated Protein Kinase(AMPK) |
Реактивность подтвержденная Нужна другая реактивность? |
человек, мышь, крыса |
| Реактивность предсказываемая |
корова, лошадь, овца, кролик, собака, курица |
| Источник (хозяин) |
кролик |
| Изотип |
IgG |
| Клональность |
поликлональное |
| Рекомбинантное |
нет |
| Готовое к использованию |
нет |
| Концентрация |
1 мг/мл |
| Конъюгат |
нет |
| Валидировано для |
Иммуногистохимия; Вестерн-блоттинг; Иммунофлуоресценция; Иммуноцитохимия |
| Рекомендуемые разведения |
WB: 1:500-1:2000; IHC: 1:50-1:200; IF/ICC: 1:100-1:500; Оптимальное разведение определяется конечным потребителем |
| Метод очистки |
Антитела получены из очищенной сыворотки кролика путем аффинной очистки с помощью последовательной хроматографии на фосфопептидных и нефосфопептидных аффинных колонках |
| Состав буфера |
Rabbit IgG в PBS; pH 7.4; 150mM NaCl; 0.02% азид натрия и 50% глицерин |
| RRID |
AB_2834846 |
| Условия доставки |
Термобокс с аккумуляторами холода |
| Условия хранения |
Хранить при -20ºС. Стабилен 12 месяцев с даты получения |
| Срок хранения |
12 месяцев |
| Производитель |
Affinity |
| Ссылка на страницу товара на сайте производителя |
https://www.affbiotech.com/goods-1592-AF3494-Phospho_AMPK_beta_1_Ser181_Antibody.html |